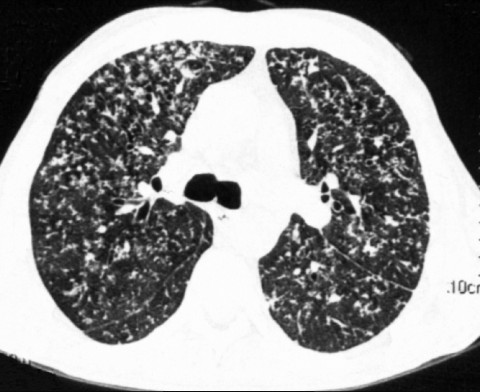
КТ при туберкулезе легких

Когда назначают томографию легких
В грудной клетке человека сосредоточены наиважнейшие органы, обеспечивающие жизнедеятельность человека – сердце, легкие, аорта, крупные артерии и лимфатические узлы. Нарушение в их работе чревато возникновением серьезных заболеваний, которые при позднем диагностировании могут иметь фатальный исход.
Большинство патологических изменений обнаруживаются при первоначальных обследованиях грудной клетки – при прохождении рентгеноскопии или флюорографии. На снимках можно рассмотреть очаги воспаления, травматические повреждения, развивающиеся новообразования. Для более детального исследования размеров и структуры деструктивных элементов или опухолей пациенту назначается высокоточное сканирование с помощью компьютерной томографии. Также КТ проводится в целях оперативной корректировки проводимого лечения и решения вопроса о необходимости хирургического вмешательства.
КТ легких: показания
Томографию легких для первичной постановки диагноза назначают, если у пациента наблюдается:
- длительный кашель, в том числе с кровью и нетипичным отделяемым;
- непрекращающаяся лихорадка, постоянно повышенная температура тела;
- головные, мышечные боли невыясненного происхождения;
- синюшность губ, кожных покровов;
- общая слабость, быстрая утомляемость;
- боли в груди ноющего и острого характера.
Велика диагностическая ценность КТ при оценке эффективности противоопухолевой терапии. Практически моментальное получение результатов обследования позволяет быстро скорректировать тактику лечения.
В каком случае еще назначают КТ легких? Диагностика может быть показана при травмах грудной области, в том числе сопровождающихся пневмотораксом (разрывом легочной ткани), кровотечениями, при выявлении на рентгенографии патологических очагов, свидетельствующих о пневмонии, эмфиземе, абсцессах, при увеличении внутригрудных лимфоузлов.
Стоит заметить, что назначение на КТ выдает лечащий врач. Он же указывает на необходимость использования контраста и ставит окончательный диагноз.
Что показывает КТ органов грудной клетки
Визуализация при КТ грудной полости показывает:
- инфекционные болезни – воспаление плевры, туберкулез, пневмония;
- прогрессирование опухолей и распространение метастазов;
- сосудистые патологии – аневризмы, тромбоэмболии, сужение артерий (стенокардия);
- наличие воздуха в легких (пневмоторакс) или выпота в плевральной полости;
- нарушения в работе сердечной мышцы, изменение размеров сердца;
- заболевания бронхолегочной системы – эмфизема, бронхоэктатическое состояние;
- увеличение/воспаление лимфоузлов, расположенных в средостении;
- патологические процессы и новообразования в молочных железах.
Аппараты для спиральной и мультиспиральной томографии позволяют получить серию плоскостных срезов, величина которых составляет от 1 до 3 мм.
Как компьютерная томография легких определяет рак
 Сканирование на компьютерном томографе – основная методика, используемая при диагностировании рака легких. Стандартный протокол КТ грудной клетки без контраста способен распознать как одиночные очаги поражения раком, так и консолидированные участки.
Сканирование на компьютерном томографе – основная методика, используемая при диагностировании рака легких. Стандартный протокол КТ грудной клетки без контраста способен распознать как одиночные очаги поражения раком, так и консолидированные участки.
Для более точного определения прогрессирования онкологического процесса используется спиральная/мультиспиральная КТ с введением контрастирующего вещества. При таком способе тестирования возможно выявление узелков, равных толщине среза – 1,5-2 мм. Если учесть, что обычный рентген фиксирует образования размером от 5 мм, то МСКТ легких дает возможность обнаружить опухоль на самой ранней стадии и вовремя приступить к лечению.
Мультиспиральная КТ с контрастным дополнением обнаруживает не только первичный рак легких и его стадию, но и ареал распространенности метастазов, прорастающих из других органов.
КТ с подозрением на рак легких нацелено на определение следующих характеристик:
- контуры, размеры и локализация новообразования;
- происхождение опухолевых узлов;
- наличие деструктуризации легочной ткани;
- проникновение неопластических образований в корень легкого и область средостения.
КТ позволяет с высокой точностью дифференцировать рак легкого от иных заболеваний – доброкачественной опухоли, кист любого генеза, абсцесса, поражений диафрагмы.
КТ диагностика рака легких
Единичные очаги, выявленные с помощью КТ, чаще всего являются признаками начинающегося онкологического заболевания. Можно ли только по описанию КТ поставить диагноз рак легких? На фото КТ рак легкого может быть обнаружен, начиная с «нулевой» стадии – когда раковые клетки сконцентрированы только в верхних слоях дыхательных путей. При проведении скрининга на изображениях отчетливо различаются одиночные узелки размытой или округлой формы, диаметр которых составляет 1-3 см.
Подобные очаги предварительно могут говорить о наличии злокачественного образования – аденокарциномы, крупно- и мелкоклеточного рака легкого. В заключении КТ врач описывает расположение очагов и их размер, фиксирует, как выглядят метастазы (при их наличии). На основании расшифровки КТ должна быть проведена биопсия легочной ткани и после получения результатов анализа выставляется окончательный диагноз. Установить в заключении периферический рак легкого на основании КТ-тестирования, без дополнительных исследований, можно только в запущенной стадии заболевания.
Опухоли в легких не всегда носят злокачественный характер. Очаговые поражения характерны и для доброкачественных новообразований, которые эффективно лечатся после обнаружения. К таким заболеваниям относится саркоидоз, который часто «маскируется» под рак легкого или туберкулез. Раннее распознавание этой болезни приводит к полному выздоровлению, в то время как запущенные стадии характеризуются распространением фиброзной ткани и легочной недостаточностью.
Покажет ли компьютерная томография саркоидоз? Да, на компьютерных снимках можно проследить характерные для этой болезни очаговые изменения – симметричные уплотнения, расположенные вдоль сосудов, бронхов или плевральных листков. Зоны уплотнения при саркоидозе имеют вид матового стекла, что хорошо различается при визуализации на КТ.
Одиночными очаговыми уплотнениями на КТ-снимках характеризуется доброкачественное врожденное заболевание – гамартома легкого. Этот вид опухоли образуется в период эмбриогенеза и говорит о пороке развития бронхолегочной системы. КТ-диагностика легко выявляет такие новообразования и помогает дифференцировать их от злокачественных опухолей.
Множественные мелкие очаги на КТ в верхней части легких и вдоль плевры в совокупности с утолщением лимфоузлов средостения сигнализируют о наличии злокачественного новообразования, именуемого лимфома. Это заболевание отличается длительным отсутствием симптоматики и обнаруживается только лучевыми методами диагностики.
Что показывает КТ средостения
Средостение – центральная часть грудной клетки, в которой располагаются сердце, пищевод, нервные и лимфатические узлы, крупные сосуды. Комьютерная томография средостения призвана обнаружить следующие патоморфологические изменения:
- новообразования в лимфоузлах (лимфоаденома, лимфогранулематоз);
- опухоль или киста вилочковой железы;
- анормальное расширение аорты (аневризма);
- воспаление, киста, дивертикулез перикарда;
- абсцессы или флегмоны мягких тканей средостения;
- болезни сердца и сосудов (поражение оболочки сердца, сердечной мышцы, клапанов, эндокарда);
- поражение пищевода – опухоли, кисты, наличие дивертикул.
КТ средостения эффективно при распознавании центрального рака легких, саркоидозе, туберкулезе. Значительное преимущество этого метода диагностики – в его неинвазивности и высоком уровне точности.
Что выявляет КТ сердца
КТ-сканирование спирального/мультиспирального типа позволяет получить трехмерные снимки сердца, выполненные с минимальной толщиной плоскостного среза. При этом достоверно распознаются следующие дефекты сердечно-сосудистой системы:
- изменения в сосудах ишемического происхождения;
- тромбоз артерий, атеросклероз сосудов;
- инфаркт миокарда, наличие постинфарктных рубцов;
- воспалительный процесс в перикарде сердца;
- наличие жидкости или кровяных сгустков в сердечных клапанах;
- дисплазия желудочков;
- врожденные аномалии развития сердечного аппарата.
Стандартное односрезовое КТ-исследование применяется для получения общей картины состояния сердца и коронарных артерий. Точная диагностика возможна только при использовании мультиспиральной КТ с контрастирующим йодсодержащим веществом. Диагностика отображает степень стеноза вен и артерий, выявляет их проходимость. Такая методика эффективна и при определении причины болей в сердце, при подготовке к операции по установке шунтов/стентов в коронарные артерии.
Очаговые изменения в легких на КТ
Поскольку толщина тестируемого слоя при КТ составляет 1-2 мм, на изображениях, полученных при обследовании хорошо различимы очаговые образования в легких, характерные для многих серьезных заболеваний.
Норма на КТ легких описывает следующие структуры грудной клетки и их параметры:
- легочные поля и контуры грудной клетки;
- состояние плевры и отсутствие скоплений (гнойный секрет/жидкость);
- расположение средостения – без расширения или смещения;
- отсутствие новообразований в области средостения;
- увеличенные размеры лимфатических узлов средостения – не фиксируются;
- доли и сегменты легких не дифференцируются, отсутствуют свежие или давние единичные очаги уплотнения.
Очаговые образования характерны для туберкулеза, опухолевых заболеваний, осложненных видов пневмонии. Первичная диагностика с помощью рентгена или флюорографии выявляет очаги, имеющие размер более 10 мм, эффективность распознавания одиночных уплотнений при этом составляет не более 1%. Именно поэтому проведение динамичного КТ (с добавлением контрастирующего вещества) является наиболее результативным способом ранней диагностики патологии органов дыхания.
Виды очаговых образований
Легочные очаги классифицируются по размерам, местоположению, плотности и численности (распространенности). Уплотнения в легких на компьютерной томографии варьируются от 1-2 до 10-15 мм, местом их расположения может быть интерстиция (легочная ткань), плевра, стенки бронхов и сосудов.
Скрининг легких показывает, что до 80% очаговых образований носит доброкачественный характер, особенно при диффузном распространении узелков. Очаги появляются в результате воздействия следующих факторов:
- кальцинаты – вследствие перенесенных воспалительных заболеваний;
- фиброз любой этиологии (разрастание соединительной ткани);
- грибковое поражение легких (кандидоз, бластомикоз, криптококкоз и др.);
- гематомы и ушиб легкого;
- нарушение проходимости дыхательных путей – ателектаз легкого.
На КТ-снимках очаговые изменения могут выглядеть, как затемнения округлой/размытой формы или осветленные зоны. Так, одним из осложнений при хроническом бронхите может быть увеличение воздухосодержащих пузырьков. При проведении КТ эмфизема легких визуализируется в виде нарушения легочного рисунка и распространения зон «прозрачности». Здоровая легочная ткань имеет плотную структуру с четко очерченными краями, в то время как участки с эмфиземой отличаются повышенной воздушностью.
Незаменимо компьютерно-томографическое исследование при осложнениях бронхолегочной системы, вызванных острым состоянием пациента – интоксикацией, почечной недостаточностью, инфарктом миокарда. КТ выявляет отек легких, который при несвоевременной диагностике может привести к фатальному исходу.
Метастазы в легких на КТ с контрастом
Эффективность выявления метастазов в легких при проведении КТ-скрининга достигает 55-60%. Усиление контрастирующим веществом проводится для получения более отчетливых изображений, на которых можно определить локализацию метастазов и степень их прорастания в соседние органы.
Легкие могут выступать местом сосредоточения метастазов при злокачественных новообразованиях других органов, поскольку по лимфатическим сосудам в область средостения легко попадают раковые клетки. Проведенная КТ с контрастом распознает метастазы, диаметр которых не превышает 0,5 см. При этом одиночные метастатичные очаги не несут никаких симптомов и могут быть выявлены только при контрольном КТ, в ходе лечения рака легких. Множественные очаговые поражения при метастазах сопровождаются ухудшением самочувствия и усилением кашля, одышки.
КТ при туберкулезе легких
Диагностирование туберкулеза легких выполняется на основании данных компьютерной томографии и результатов анализов пациента (мокрота, слюна, бронхоскопия). Для первоначального определения заболевания характерны субплевральные очаги в легких на снимках КТ – инфильтраты и уплотнения, расположенные под плеврой.
Диагностирование туберкулеза легких выполняется на основании данных компьютерной томографии и результатов анализов пациента (мокрота, слюна, бронхоскопия). Для первоначального определения заболевания характерны субплевральные очаги в легких на снимках КТ – инфильтраты и уплотнения, расположенные под плеврой.
Очаговые поражения при туберкулезе имеют вид «матового стекла» и сопровождаются увеличением лимфоузлов. При наличии подобных изменений в ходе рентгенографического обследования по КТ легких пневмония дифференцируется от первичного туберкулеза. Сканирование обнаруживает уплотнения, обсеменения или участки распада в легких диаметром от 1 мм, что дает возможность раннего распознавания болезни.
КТ-изображения дают представление о форме диагностированного туберкулеза (очаговый, диссеминированный, кавернозный, цирротический) и имеющихся в легочных тканях патологических изменениях.
Компьютерная томография при туберкулезе, как и при раке легких, активно используется не только для постановки точного диагноза, но и для мониторирования состояния больного в ходе лечения.